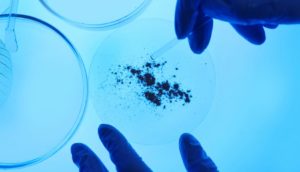
Uso degli antibiotici

Un recente studio pubblicato nell’agosto del 2013 ha evidenziato come una sbagliata prescrizione di antibiotici, intesa anche come errata posologia, sia responsabile di circa 400.000 morti l’anno nel mondo e di una spesa sanitaria pari a circa 30 bilioni di dollari. Lo studio ha evidenziato come la semplice conoscenza delle più semplici linee guida in termini di terapia possa migliorare drasticamente la situazione. Tutti i clinici ed i ricercatori erano concordi nel sostenere che non è tanto l’introduzione di nuovi antibiotici ma un uso migliore di quelli già presenti che può migliorare la salute dei pazienti.
A questo proposito si ricorda ai pazienti di evitare un’auto prescrizione o di sospendere la terapia antibiotica quando si sentono meglio ma di rivolgersi allo specialista per una diagnosi appropriata ed altrettanto appropriata terapia.
Se non verranno prese misure adeguate, entro il 2050 la resistenza agli antibiotici potrebbe rappresentare una causa di morte più pericolosa del cancro, portando alla morte di 10 milioni persone ogni anno nel mondo. La minacciosa previsione è contenuta in un resistance) commissionato dal Governo britannico alle autorità sanitarie inglesi. Una “apocalisse farmacologica” che, in realtà, potrebbe essere più vicina di quanto si possa immaginare.
Il fenomeno dell’antibiotico resistenza ha avuto origine, tra le altre cose, nell’uso eccessivo e spesso scorretto e incompleto di questi farmaci. La situazione in cui ci si trova oggi ci obbliga a un cambio di prospettiva. È indispensabile infatti che sia i medici che i pazienti imparino a usare gli antibiotici con appropriatezza. La terapia antibiotica deve essere portata a termine nel modo prescritto dal medico e non interrotta quando la sintomatologia è scomparsa. Gli antibiotici vanno presi ad alte dosi e per periodi generalmente brevi (4-6 giorni) e l’impiego deve essere mirato in base al batterio che ha causato la patologia.
Antibiotic Resistance 2013, A Global Survey